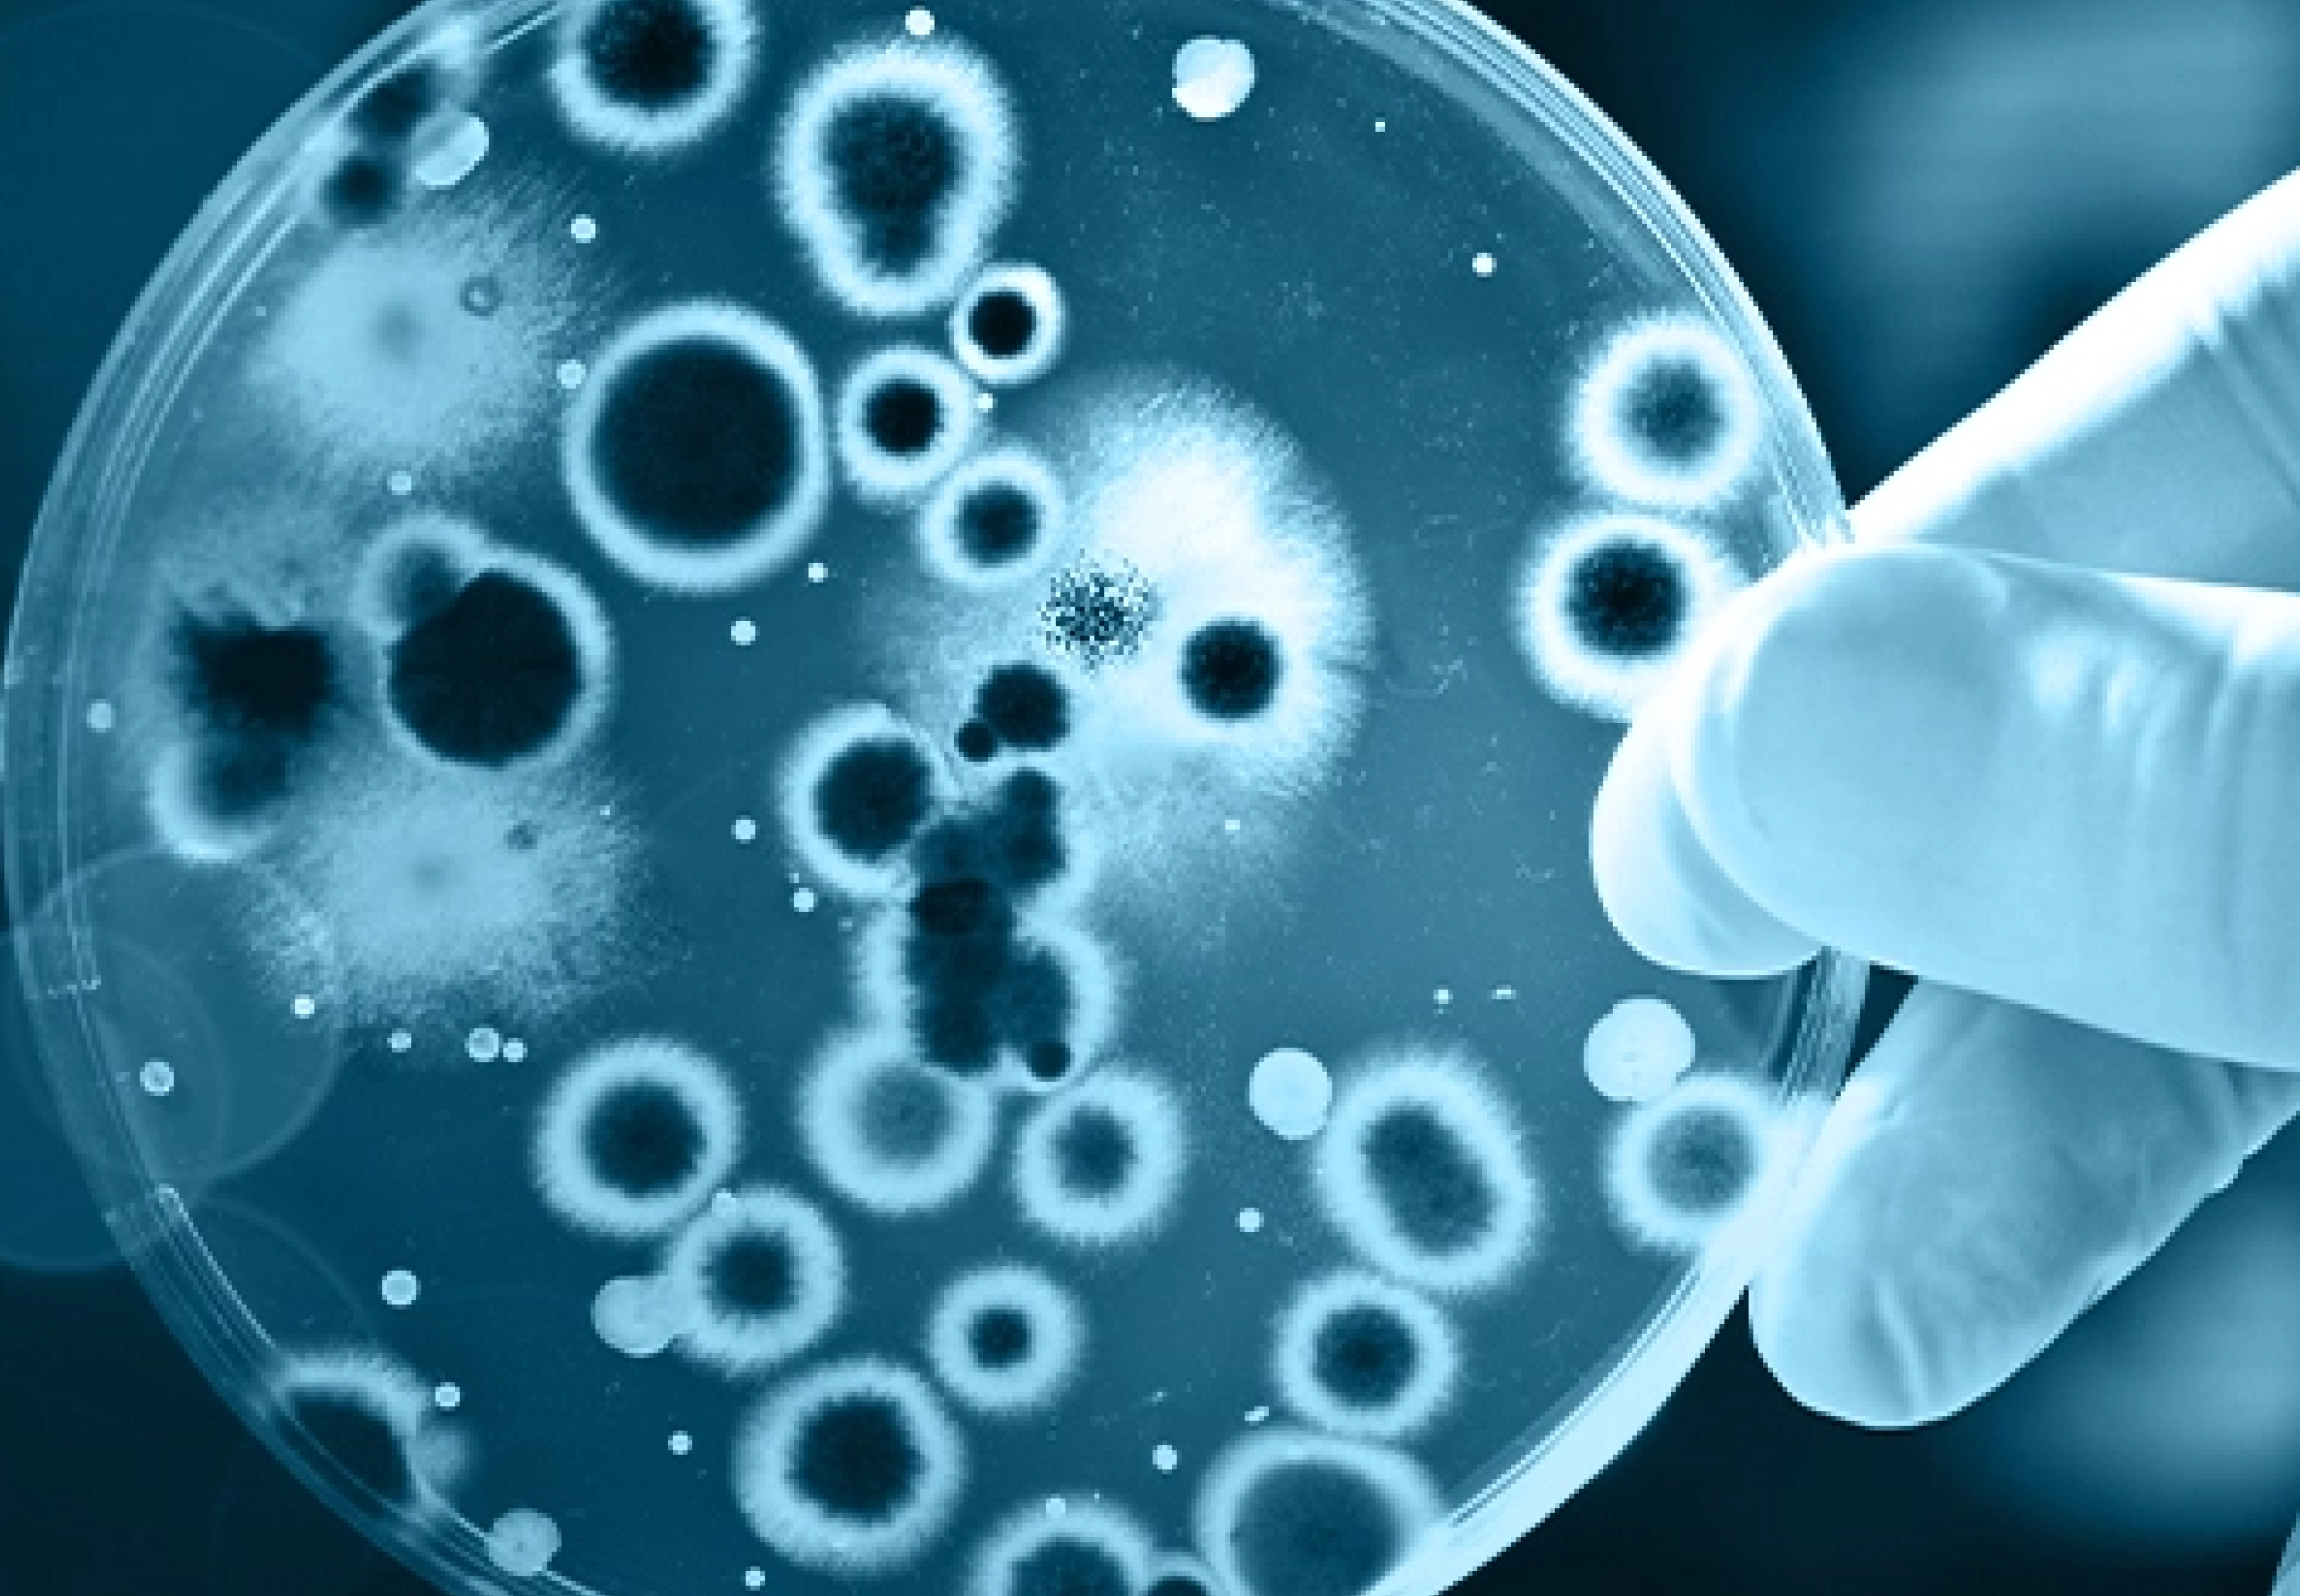

Other services we offer to our partners for freeing up their resources from Non-Innovation led activities.
Protocol preparation for validation, Qualification, Microbiological studies etc.

Microbiological data and Report review
Report preparation from the raw data

Organize fit for purpose accredited CRO/Testing laboratories for specialized needs on Microbiology

Creating training modules and competency assessment plan
